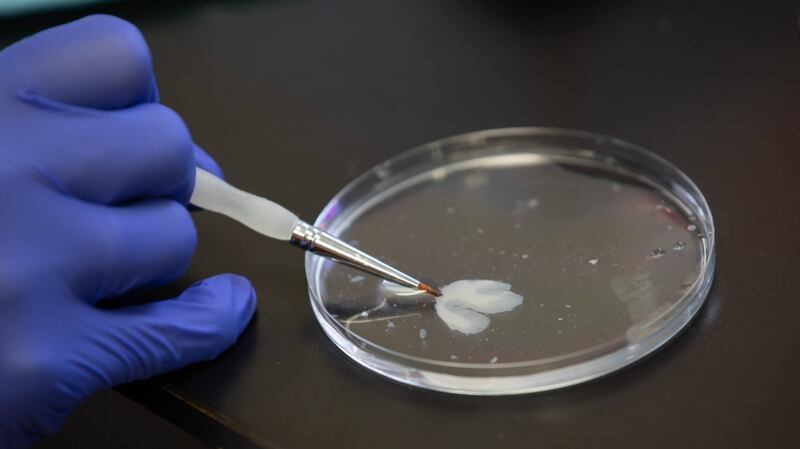

Les chercheurs affirment qu'il est aussi difficile de jeter un coup d'œil à l'intérieur du cerveau d'une personne que de comprendre l'univers ou de découvrir l'océan dans son intégralité.
Néanmoins, ils continuent à avancer, tout cela au nom de la science.
Ce texte est une traduction d’un article de CTV News.
«Le cerveau est un organe fascinant, affirme la Dre Viviane Poupon, présidente-directrice générale de Brain Canada. Je pense que nous n'expliquons pas suffisamment au public la complexité de son fonctionnement. Il y a de nombreuses connexions entre les neurones et les différentes cellules que nous avons».
Brain Canada est un organisme à but non lucratif créé en 1998, qui s'appelait alors NeuroScience Canada Partnership and Foundation.
«Notre objectif est de soutenir la recherche sur le cerveau, de mieux comprendre le fonctionnement du cerveau dans la santé et la maladie, et de soutenir l'ensemble de l'écosystème canadien. Il est vraiment très important que nous fassions des découvertes révolutionnaires sur notre cerveau. C'est donc notre mission principale», a déclaré la Dre Poupon.
Selon elle, l'objectif est simple: permettre aux Canadiens de vivre avec un cerveau aussi sain que possible, le plus longtemps possible.
«Il faut aussi essayer de trouver des points communs, car c'est parfois le même mécanisme qui est à l'origine de différentes maladies neurodégénératives. Il faut comprendre ces moteurs parce qu'ils peuvent avoir des implications dans une maladie ou une autre», explique-t-elle.
Une partie importante de la science, explique Mme Poupon, consiste à comprendre comment le cerveau interagit avec le reste du monde.
«C'est pourquoi nous soutenons toutes sortes de recherches sur le cerveau. Nous avons une approche holistique du cerveau. Nous le considérons comme un tout, a-t-elle déclaré. Il ne s'agit pas seulement de ce qui se passe entre nos oreilles de manière isolée; notre cerveau réagit en permanence à notre environnement interne et à notre environnement externe.»
Mme Poupon note que la recherche porte sur tous les aspects, de l'interaction entre les cellules à la formation de la mémoire, en passant par la manière dont ces mécanismes peuvent s'effondrer avec le temps.
«Pourquoi un cerveau normal et sain prend-il soudainement une trajectoire différente et commence-t-il à développer une maladie?»
L'un des principaux collaborateurs de Brain Canada est la banque de cerveaux du Centre de recherche Douglas à Montréal.
Il s'agit d'une collection de 4000 cerveaux donnés par des personnes dont beaucoup ont souffert de diverses maladies neurodégénératives comme la maladie de Parkinson, la maladie d'Alzheimer, la démence et la sclérose latérale amyotrophique.
«Le cerveau demeure un organe du corps humain mal connu, explique le Dr Gustavo Turecki, directeur scientifique du Centre de recherche du Douglas. Nous comprenons encore très peu de choses sur le fonctionnement du cerveau : à quel endroit du cerveau certains processus sont régulés, comment nos émotions et nos comportements sont régulés et ce qui se passe lorsque les choses ne fonctionnent pas bien».
La banque analyse également le cerveau de personnes souffrant de maladies mentales telles que la schizophrénie, la dépression, les troubles bipolaires, etc.

L'un des principaux défis de l'étude du cerveau?
«La seule façon de vraiment comprendre est d'avoir accès au tissu cérébral. Malheureusement, il n'est pas possible de prélever des tissus cérébraux sur des sujets vivants», explique M. Turecki.
Il note que l'âge, le sexe, l'origine ethnique et même l'environnement peuvent affecter différemment le cerveau des personnes.
«Différents laboratoires et différents chercheurs qui posent des questions différentes ont trouvé des choses différentes, explique-t-il. Il y a tellement de choses qui ont été impossibles à trouver jusqu'à présent... sans le tissu cérébral que nous avons dans la banque, cela aurait été impossible».
Il admet que l'obtention du consentement à l'analyse du cerveau d'une personne est une question «délicate».
«Nous avons besoin du consentement immédiatement après le décès, car le cerveau doit être prélevé dans les 24 ou 48 heures au maximum. Même s'ils vivent une expérience très difficile, [ils] donnent le cerveau qui peut aider d'autres familles à éviter ce qu'elles vivent... Nous aidons à comprendre pourquoi quelqu'un est mort», explique-t-il
M. Poupon ajoute que Brain Canada espère que la recherche mènera éventuellement à de meilleurs diagnostics et à l'identification de biomarqueurs afin de créer des traitements plus prometteurs pour les personnes vivant avec le spectre des troubles cérébraux.
«Il s'agit d'une richesse collective mise à la disposition des chercheurs du Canada et du monde entier pour répondre aux questions concernant ce que je découvre, ce que j'observe dans mon laboratoire, dans une cellule ou dans un modèle animal: est-ce vraiment ce qui s'est passé chez un être humain?»
En ce qui concerne l'avenir, Mme Poupon se dit «très impatiente» de voir ce que les chercheurs découvriront au cours de la prochaine décennie.


